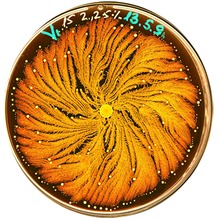

بينيباسيلس فورتكس Paenibacillus vortex
| بينيباسيلس فورتكس Paenibacillus vortex | |
|---|---|
| |
| الشكل 1: تنظيم مستعمرة للP. فورتكس البكتيريا عندما نمت على 15G / لتر البيبتون و2.25٪ (W / V) آجار لمدة أربعة أيام. النقاط صفراء زاهية هي الفورتيسات ونمت المستعمرات في حجم 8.8cm طبق بتري وملطخة الأصباغ Coomassie (الزرقاء الرائعة). وقد عكست الألوان إلى التأكيد على أعلى كثافة لإستخدام أكثر إشراقا ظلالا من اللون الأصفر. | |
| التصنيف العلمي | |
| Class: | |
| Order: | |
| Family: | |
| Genus: | Paenibacillus Ash et al. 1994
|
| Binomial name | |
| Paenibacillus vortex | |
| Synonyms | |
|
Bacillus vortex Ash et al. 1994 | |
Paenibacillus vortex هو نوع من نمط تشكيل البكتريا ، اكتشف لأول مرة في ال 90 في وقت مبكر من قبل مجموعة بن يعقوب .[1] بل هو من الكائنات الحية الدقيقة الإجتماعية التى تكون مستعمرات ذات هيكلية ديناميكية معقدة .الجنس Paenibacillus يشمل ميكروبا موجب الجرام متطفل لاهوائى الباكتيريا المنتجة للإندوسبور مدرجة أصلا ضمن جنس العصويات ومن ثم تم تصنيفها بوصفها جنسا مستقلا في عام1993 .[2] تم اكتشاف البكتيريا التي تنتمي الى هذا الجنس في مجموعة متنوعة من البيئات، مثل: التربة والمياه , الريزوسفير, المخلفات النباتية, العلف والحشرات و ال يرقات, وكذلك عينات سريرية.[3][4][5][6] وجدت أساسا في بيئات متباينة ومعقدة، مثل التربة، والريزوسفير.
تشكل الأنماط والسلوك الاجتماعي
بينيباسيلس فورتكس هو كائن حي دقيق إجتماعى: عندما نما في ظل ظروف النمو التي تحاكي البيئات الطبيعية مثل الأسطح الصلبة أنها تشكل مستعمرات الخلايا 109-1012 مع البنى المعقدة بشكل ملحوظ والديناميكية (الشكل 1) <." />[7][8] كونها جزءا من تعاونية كبيرة، لا يمكن للبكتيريا تنافس أفضل للموارد الغذاء والحماية من الهجمات المضادة للبكتيريا.[9][7] في ظل ظروف نمو مختبر، مماثلة لبكتيريا الاجتماعية الأخرى،مستعمرات بينيباسيلس فورتكس تتصرف مثل الكثير من الكائنات الحية متعددة الخلايا، مع تمايز الخلايا وتوزيع المهام[10].[11][12][13] بينيباسيلس فورتكس يتميز دوامة من خلال قدرته على توليد مجاميع خاصة ببكتيريا كثيفة قد دفعت إلى الأمام عن طريق إشارات كيميائي مثيرة للاشمئزاز مرسلة من الخلايا في الجزء الخلفي.[8][14][15][16][17][18] هذه المجاميع الدورية تسمى دوامية verices (الشكل 2)، وتمهد الطريق لتوسيع المستعمرة. والدوامات بمثابة اللبنات من المستعمرات مع تنظيم وحدات خاصة (الشكل 1). تحقيق مثل هذه المشاريع التعاونية معقد ويتطلب تطور إتصال خلية خلية ,[7][13][19][20][21] بما في ذلك الجوانب الدلالية والبراغماتية للغويات.[13]التواصل مع بعضهم البعض باستخدام مجموعة متنوعة من الإشارات الكيميائية، والبكتيرية وتبادل المعلومات بشأن حجم البكتريا من حيث العدد، وعدد لا يحصى من القياسات البيئية فرد في مواقع مختلفة، والدول الداخلية وتعديلاتها المظهرية والجينية. البكتيريا تشعر بالبيئة بصفة جماعية وتنفيذ وتعالج المعلومات الموزعة لجمع وتقييم المعلومات ذات الصلة.[7][13][22] ثم يتم استخدام هذه المعلومات من قبل البكتيريا لإعادة تشكيل مستعمرة في حين إعادة توزيع المهام والتفرقة جينية الخلية، لصنع القرار الجماعي وتشغيل وإيقاف تشغيل آليات الدفاع وجريمة اللازمة لتزدهر في بيئات تنافسية، والكليات التي يمكن أن ينظر إليها على أنها الذكاء الاجتماعي من البكتيريا.[13]
أذكى نوع بكتيري على كوكب الأرض؟
أحد أنواع الميكروبات الموجودة في التربة يمكنه اتخاذ قرارات حكيمة على غير العادة وذلك عند تواصله مع البيئة المحيطة به
لا يقتصر اهتمام E. بن-جاكوب، أستاذ الفيزياء في جامعة تل أبيب على جينومات genomes البكتيريا التي يدرسها فحسب، وإنما يهتم أيضا بدراسة شخصياتها. إنه يقارن البكتيريا بمشاهير هوليود. «فمن ناحية، نحن معجبون بالبكتيريا، ولكننا من ناحية أخرى نعتقد أنها كائنات غبية،» عـلى حد قول <بن-جاكوب>. لقد تمكن <بن-جاكوب> وزملاؤه من نشر بحث في العدد 12/2010 من مجلة BMC Genomics سجلوا فيها أن أحد أنواع بكتيريا التربة، ويسمى پيانيباسلس ڤورتكس Paenibacillus vortex والذي اكتشفه <بن-جاكوب> في منتصف التسعينات، يتميز بمستوى مدهش من الذكاء وذلك مقارنة بالميكروبات الأخرى.
وقد تمكن الفريق البحثي من تعرف هذا الذكاء النسبي للنوع پيانيباسلس ڤورتكس عن طريق مقارنة الجينوم الخاص به بجينوم 502 نوع بكتيري مختلف تم تعرفها خلال السنوات الماضية، وتأسيسا على هذه المقارنة تم حساب ما يطلق عليه بن-جاكوب معامل الذكاء الاجتماعي للميكروب(1). حيث قام الباحثون بتقدير عدد الجينات (الموروثات) genes المرتبطة بالوظائف الاجتماعية مثل الجينات التي تسمح للبكتيريا بالتواصل مع البيئة المحيطة بها والتعامل مع ما يصلها منها من معلومات، وكذلك الجينات التي تعمل على بناء مركبات كيميائية مفيدة للميكروب عند تنافسه مع الميكروبات الأخرى. وقد وُجد أن پيانيباسلس ڤورتكس وسلالتين أخريين من جنس پيانيباسلس تحتوي على عدد من هذه الجينات أكبر مما لدى أي نوع آخر من الـ499 نوعا بكتيريا التي قام <بن-جاكوب> بدراستها، ومن ضمنها سلالات ممرضة من بكتيريا الإشريكية القولونية Escherichia coli، وهذا يدل على امتلاك الميكروب «مهارات اجتماعية ذكية.»
ويتجلى هذا التعقد بالمهارات الاجتماعية في المستعمرات ذات التفاصيل المميزة التي يقوم الپيانيباسلس ڤورتكس بتكوينها، وتظهر إحداها في الصورة الفوتوگرافية المصاحبة لهذا المقال، وذلك بعد تنميتها لأيام عديدة في طبق بتري(2) petri dish. ويصل قُطْرُ هذه المستعمرة إلى نحو 8 سنتيمترات، ولكن عدد ما فيها من خلايا بكتيرية أكثر بمئة مرة من عدد سكان الأرض. وتمثل النقاط الزرقاء في الصورة مجموعات كثيفة من هذه البكتيريا يطلق عليها «الدوامات» vortices، وهي تنتشر وتتجمع سويا حول مركز مشترك لكي تمهد طريق البكتيريا على السطوح الصلبة ولتحمي نفسها من الأخطار. ومع تضاعف الخلايا فإن كل «دوامة» تزداد في الحجم وتتحرك إلى الخارج كوحدة واحدة، تاركة خلفها ذيلا من خلايا أكبر عمرا لا تقوم بالتضاعف، ولكنها تعمل على تكوين أفرع تقوم بالمحافظة على التواصل الاجتماعي عبر المستعمرة.
الهامش
- ^ Ben-Jacob E, Shochet O, Tenenbaum A, Avidan O (1995). "Evolution of complexity during growth of bacterial colonies". NATO Advanced Research Workshop; Santa Fe, USA. Edited by Cladis PE, Palffy-Muhorey P. Addison-Wesley Publishing Company;: 619–633.
{{cite journal}}: CS1 maint: extra punctuation (link) CS1 maint: multiple names: authors list (link) - ^ Ash C, Priest FG, Collins MD: Molecular identification of rRNA group 3 bacilli (Ash, Farrow, Wallbanks and Collins) using a PCR probe test. Proposal for the creation of a new genus Paenibacillus. Antonie Van Leeuwenhoek 1993, 64:253-260.
- ^ Lal S, Tabacchioni S: Ecology and biotechnological potential of Paenibacillus polymyxa: a minireview. Indian J Microbiol 2009, 49:2-10.
- ^ McSpadden Gardener BB: Ecology of Bacillus and Paenibacillus spp. in Agricultural Systems. Phytopathology 2004, 94:1252-1258.
- ^ Montes MJ, Mercade E, Bozal N, Guinea J: Paenibacillus antarcticus sp. nov., a novel psychrotolerant organism from the Antarctic environment. Int J Syst Evol Microbiol 2004, 54:1521-1526.
- ^ Ouyang J, Pei Z, Lutwick L, Dalal S, Yang L, Cassai N, Sandhu K, Hanna B, Wieczorek RL, Bluth M, Pincus MR: Case report: Paenibacillus thiaminolyticus: a new cause of human infection, inducing bacteremia in a patient on hemodialysis. Ann Clin Lab Sci 2008, 38:393-400.
- ^ أ ب ت ث Ben-Jacob E: Bacterial self-organization: co-enhancement of complexification and adaptability in a dynamic environment. Phil Trans R Soc Lond A 2003, 361:1283-1312.
- ^ أ ب Ben-Jacob E, Cohen I, Gutnick DL: Cooperative organization of bacterial colonies: from genotype to morphotype. Annu Rev Microbiol 1998, 52:779-806.
- ^ خطأ استشهاد: وسم
<ref>غير صحيح؛ لا نص تم توفيره للمراجع المسماةingham - ^ Aguilar C, Vlamakis H, Losick R, Kolter R: Thinking about Bacillus subtilis as a multicellular organism. Curr Opin Microbiol 2007, 10:638-643.
- ^ Dunny GM, Brickman TJ, Dworkin M: Multicellular behavior in bacteria: communication, cooperation, competition and cheating. Bioessays 2008, 30:296-298.
- ^ Shapiro JA, Dworkin M: Bacteria as multicellular organisms. 1st edn: Oxford University Press, USA; 1997.
- ^ أ ب ت ث ج Ben-Jacob E, Becker I, Shapira Y, Levine H: Bacterial linguistic communication and social intelligence. Trends Microbiol 2004, 12:366-372.
- ^ Ben-Jacob E: From snowflake formation to growth of bacterial colonies II: Cooperative formation of complex colonial patterns. Contem Phys 1997, 38:205 - 241.
- ^ Ben-Jacob E, Cohen I: Cooperative formation of bacterial patterns. In Bacteria as Multicellular Organisms Edited by Shapiro JA, Dworkin M. New York: Oxford University Press; 1997: 394-416
- ^ Ben-Jacob E, Cohen I, Czirók A, Vicsek T, Gutnick DL: Chemomodulation of cellular movement, collective formation of vortices by swarming bacteria, and colonial development. Physica A 1997, 238:181-197.
- ^ Cohen I, Czirok A, Ben-Jacob E: Chemotactic-based adaptive self-organization during colonial development. Physica A 1996, 233:678-698.
- ^ Czirok A, Ben-Jacob E, Cohen II, Vicsek T: Formation of complex bacterial colonies via self-generated vortices. Phys Rev E Stat Phys Plasmas Fluids Relat Interdiscip Topics 1996, 54:1791-1801.
- ^ Bassler BL, Losick R: Bacterially speaking. Cell 2006, 125:237-246.
- ^ Bischofs IB, Hug JA, Liu AW, Wolf DM, Arkin AP: Complexity in bacterial cell-cell communication: quorum signal integration and subpopulation signaling in the Bacillus subtilis phosphorelay. Proc Natl Acad Sci U S A 2009, 106:6459-6464.
- ^ Kolter R, Greenberg EP: Microbial sciences: the superficial life of microbes. Nature 2006, 441:300-302.
- ^ Dwyer DJ, Kohanski MA, Collins JJ: Networking opportunities for bacteria. Cell 2008, 135:1153-1156.

